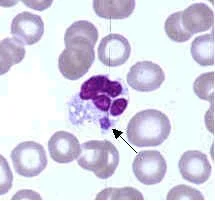

Tick Diseases
Alt text for screen readers here
I declared ticks my mortal enemies in high school when Rocky Mountain Spotted Fever (RMSF) nearly killed me. Even if they didn't carry diseases, I'd still hate them though. Aside from being extremely annoying and covering you in the most itchy bites I've experienced, they carry a lot of diseases! These diseases are nasty; many cause lasting damage and are just sheer misery!
I'll discuss three tick borne illnesses and their symptoms: Rocky Mountain Spotted Fever, Lyme Disease, and Ehrlichiosis. These are three of the most common and recognizable tick borne illnesses in the United States. These are endemic in parts of the US, Australia, Canada, and other countries.
Before we begin: check out my article on how to protect yourself from bug bites!
Rocky Mountain Spotted Fever (RMSF)
I unfortunately have too much experience with this disease - though it did help me realize my love for microbiology and public health when I was researching what was happening in my body.
RMSF is caused by the bacterium, Rickettsia rickettsii, which is a unique type of bacteria: obligate intracellular parasites. This means that in order to survive, they have to enter the host cells - which is very similar to viruses! Most bacteria can survive outside the host cells, but bacteria in the Ricketsia genus cannot; thus, it's hypothesized that these bacteria are very old and are an evolutionary bridge between viruses and bacteria.
Microbiology tangent over. RMSF is the most lethal tick disease and causes a signature spotted rash. When symptoms develop, they are FEROCIOUS.
Symptoms
Spotted rash (petechiae)
Fever
Muscle aches
Pain all over the body
Fatigue
Severe headache
Nausea
Vomiting
No appetite
RMSF is deadly if not treated! If you've been bitten by a tick recently and start developing these symptoms: go to your nearest ER or call 911 - especially if you have a fever of 103°F (39.4°C)! Early signs are nonspecific and cold or flu like, but progress rapidly.
Late stage symptoms
Very high fever (mine was 105°F!)
Organ damage and failure
Internal bleeding (the spots in the rash are from bleeding)
Loss of limbs
Lethargy and confusion
Involvement of multiple organ systems
Coma
Death
Treatment consists of doxycycline, an antibiotic, and supportive care. The infection doesn't relapse, but it can cause damage that results in disabilities, such as amputation, hearing loss, and paralysis.
When I had RMSF, I had mild cold-like symptoms that I attributed to allergies and stress for a couple of days. I went to school around 8:30AM, I started itching and a spotted rash started spreading across my body. By noon, it was over my entire body and by 2:00PM, my legs and feet were swollen and I had a headache. At 3:00PM, I needed help walking because of the severe pain.
The symptoms progress RAPIDLY!!!
Taken after the rash subsided and I was recovering
Lyme Disease
Lyme Disease is probably the first disease that people think of when they hear "tick disease". This disease is caused by the bacteria, Borrelia burgdorferi or Borrelia mayonii, and is an odd spiral shape (spirochete). This shape allows them to evade the immune system, burrow into tissues, cross the blood-brain barrier, and avoid antibiotics - which leads to it being difficult to diagnose and treat!
Symptoms
Fever
Headache
"Bullseye" rash
Fatigue
If left untreated where it's been able to burrow into tissues and get into the central nervous system, symptoms can be quite severe, such as:
Swelling in the joints
Pain, particularly nerve pain
Difficulty concentrating
Cardiovascular issues
Similar to RMSF, it's treated with doxycycline and supportive care.
There's some debate on whether Lyme Disease can be recurring. Many people have chronic health issues following an infection and medical literature supports that the damage from the infection causes a cluster of symptoms that are referred to as Post Treatment Lyme Disease Syndrome (PTLDS), rather than Chronic Lyme Disease (CLD). The key difference being that CLD would involve recurring infections, but PTLDS doesn't involve any bacteria.
Common symptoms of PTLDS
Fatigue
Joint pain
Muscle aches
Insomnia
Depression
Ehrlichiosis
Ehrlichiosis is used to describe the tick borne disease caused by Ehrlichia chaffeensis*, E. ewingii, or E. muris eauclairensis. These bacteria are related to Rickettsia rickettsii and are also obligate intracellular parasites.
Symptoms
Fever
Chills
Upset stomach
Malaise (feeling ill)
Headache
Muscle aches
Symptoms usually start 1 or 2 weeks after a bite from the pathogenic (disease causing) tick. The first 5 days of the illness may seem relatively mild, but if antibiotic treatment is delayed, it will significantly worsen.
Late stage symptoms
Damage to the brain and central nervous system, such as inflammation of the brain and surrounding tissues
Bleeding that is difficult to control
Organ failure
Death
Like Lyme Disease and Rocky Mountain Spotted Fever, it is also treated with doxycycline and supportive care.
*named for Fort Chaffee in Western Arkansas, where it was first found in blood samples
Conclusion
Most initial symptoms of diseases from tick bites are cold and flu-like. If you know that you've been bitten by a tick recently and develop mild cold-like symptoms, it is best to mention it to your healthcare providers. Diagnosis of a tick borne disease is done by a blood test (tick disease panel) and symptoms. If you are unsure if you've been bitten by a tick recently, but live in an area where it's endemic and in peak season, you should also request a tick disease panel if you begin to feel ill for more than a couple of days without improvement.
Prevention is key; early detection and treatment is the next best thing!
Special Shoutout
Did you know there's an animal that eats up to 4,000 ticks per week? They're very shy and nocturnal, but the opossum (often called "possum" in the US) is a silent superhero! They eat thousands of ticks and greatly reduce the chances of their neighbors contracting potentially lethal diseases, without getting sick themselves.
So the next time you see an opossum, thank it for its help keeping you healthy!